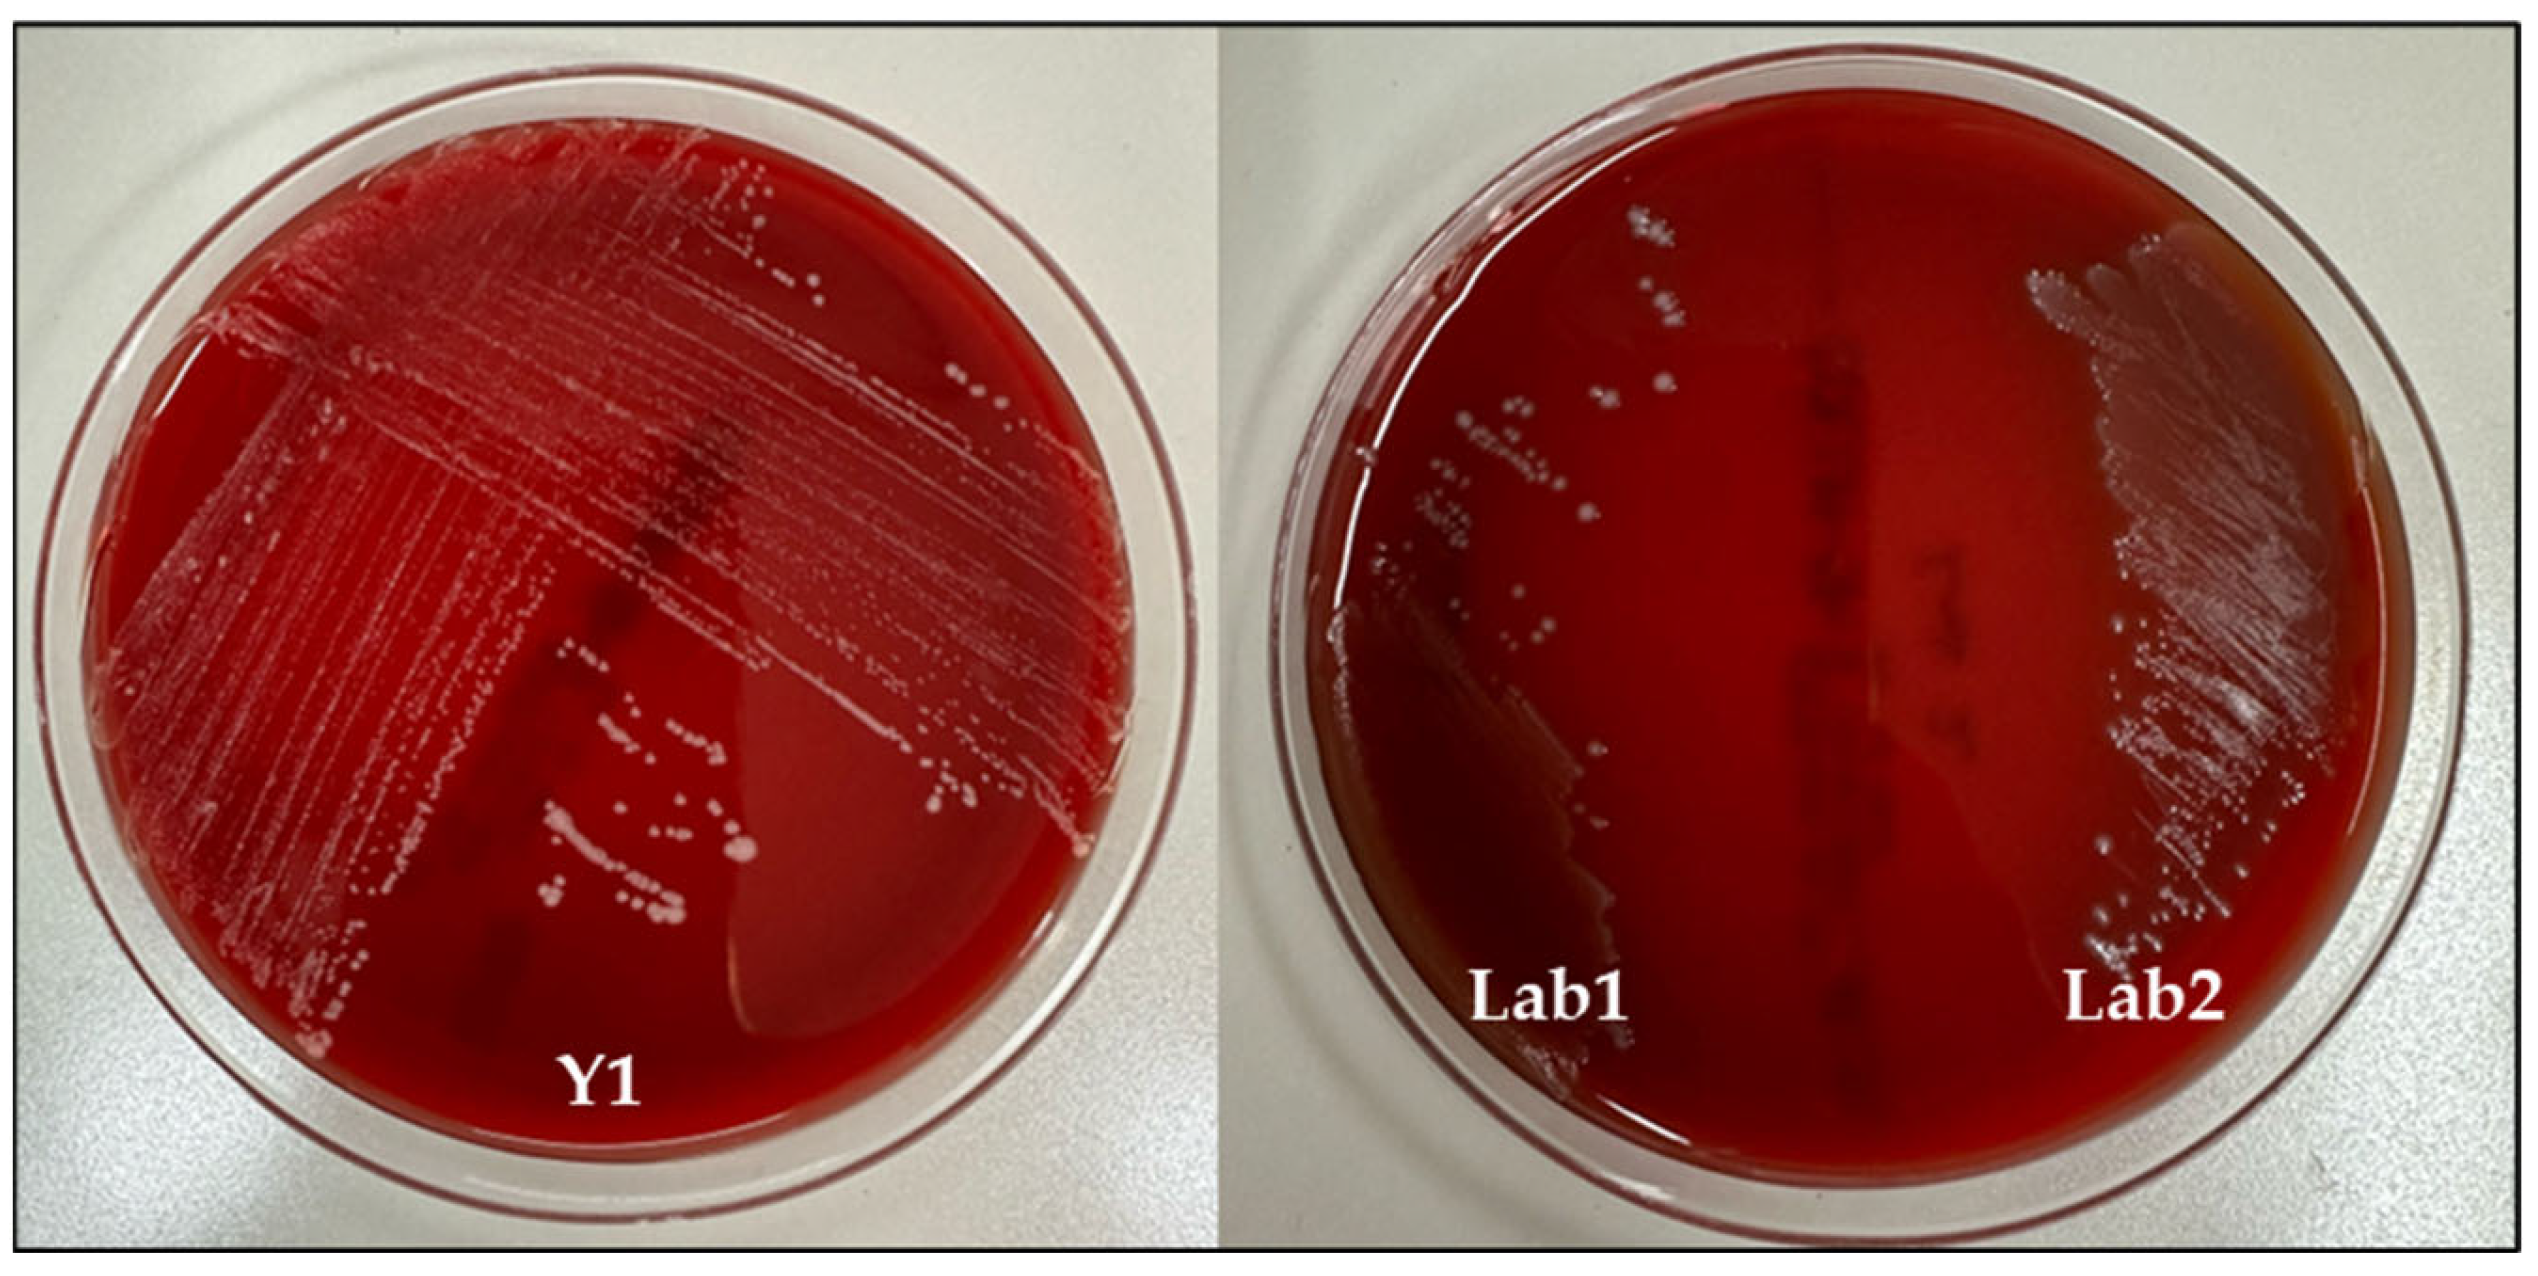
Foods 13 01013 g005

Evaluation of Potential Probiotic Properties and In Vivo Safety of Lactic Acid Bacteria and Yeast Strains Isolated from Traditional Home-Made Kefir
Abstract
1. Introduction
2. Materials and Methods
2.1. Kefir Grains
2.2. Isolation of Yeasts and LABs from Kefir Grains
2.3. Molecular Characterization of Selected Isolates
Bacterial and Fungal DNA Extraction, Amplification and Sequencing
2.4. Probiotic Evaluation
2.4.1. Acid and Bile Salt Tolerance
2.4.2. Auto-Aggregation/Co-Aggregation Capacity
2.4.3. Hydrophobicity Assays
2.4.4. Adhesion to Caco-2 Cells and HT29 Cells
2.4.5. Quantitative Assessment of Biofilm Formation
2.4.6. Preparation of Cell-Free Supernatant (CFS) and Antimicrobial Activity against Food-Borne Pathogens
2.4.7. Antioxidant Activity
2.5. Safety Assessment
2.5.1. Hemolytic Activity
2.5.2. Antibiotic and Antifungal Assistance
2.6. In Vivo Safety Analysis
2.6.1. Galleria mellonella Survival Assay
2.6.2. Burden Assay
2.7. Statistical Analyses
3. Results
3.1. Isolation and Molecular Characterization of Yeast and LABs from Kefir Grains
3.2. Survival under Simulated Gastrointestinal Tract Conditions
3.3. Auto-Aggregation and Hydrophobicity Assay
3.4. Co-Aggregative Effect of Y1, LAB1 and LAB2 against Intestinal Bacteria
3.5. Adhesion Capacity
3.6. Determination of the Optimal Biofilm Formation
3.7. Activity of CFSs against Some Food-Borne Pathogens
3.8. Antioxidant Activity
3.9. Safety Assessment
3.10. In Vivo Safety Analysis
4. Discussion
5. Conclusions
Author Contributions
Funding
Institutional Review Board Statement
Informed Consent Statement
Data Availability Statement
Conflicts of Interest
References
- Hill, C.; Guarner, F.; Reid, G.; Gibson, G.R.; Merenstein, D.J.; Pot, B.; Morelli, L.; Canani, R.B.; Flint, H.J.; Salminen, S.; et al. Expert consensus document. The International Scientific Association for Probiotics and Prebiotics consensus statement on the scope and appropriate use of the term probiotic. Nat. Rev. Gastroenterol. Hepatol. 2014, 11, 506–514. [Google Scholar] [CrossRef] [PubMed]
- Khushboo; Karnwal, A.; Malik, T. Characterization and selection of probiotic lactic acid bacteria from different dietary sources for development of functional foods. Front. Microbiol. 2023, 14, 1170725. [Google Scholar] [CrossRef] [PubMed]
- Žuntar, I.; Petric, Z.; Bursać Kovačević, D.; Putnik, P. Safety of Probiotics: Functional Fruit Beverages and Nutraceuticals. Foods 2020, 9, 947. [Google Scholar] [CrossRef] [PubMed]
- Monteiro, S.S.; Schnorr, C.E.; Pasquali, M.A.d.B. Paraprobiotics and Postbiotics—Current State of Scientific Research and Future Trends toward the Development of Functional Foods. Foods 2023, 12, 2394. [Google Scholar] [CrossRef]
- Tanhaeian, A.; Mirzaii, M.; Pirkhezranian, Z.; Sekhavati, M.H. Generation of an engineered food-grade Lactococcus lactis strain for production of an antimicrobial peptide: In vitro and in silico evaluation. BMC Biotechnol. 2020, 20, 19. [Google Scholar] [CrossRef] [PubMed]
- Sionek, B.; Szydłowska, A.; Zielińska, D.; Neffe-Skocińska, K.; Kołożyn-Krajewska, D. Beneficial Bacteria Isolated from Food in Relation to the Next Generation of Probiotics. Microorganisms 2023, 11, 1714. [Google Scholar] [CrossRef] [PubMed]
- Menezes, A.G.T.; Ramos, C.L.; Cenzi, G.; Melo, D.S.; Dias, D.R.; Schwan, R.F. Probiotic Potential, Antioxidant Activity, and Phytase Production of Indigenous Yeasts Isolated from Indigenous Fermented Foods. Probiotics Antimicrob. Proteins 2020, 12, 280–288. [Google Scholar] [CrossRef]
- Sambrani, R.; Abdolalizadeh, J.; Kohan, L.; Jafari, B. Recent advances in the application of probiotic yeasts, particularly Saccharomyces, as an adjuvant therapy in the management of cancer with focus on colorectal cancer. Mol. Biol. Rep. 2021, 48, 951–960. [Google Scholar] [CrossRef]
- Pais, P.; Almeida, V.; Yılmaz, M.; Teixeira, M.C. Saccharomyces boulardii: What Makes It Tick as Successful Probiotic? J. Fungi 2020, 6, 78. [Google Scholar] [CrossRef] [PubMed]
- Kwofie, M.K.; Bukari, N.; Adeboye, O. Probiotics Potential of Yeast and Lactic Acid Bacteria Fermented Foods and the Impact of Processing: A Review of Indigenous and Continental Food Products. Adv. Microbiol. 2020, 10, 492–507. [Google Scholar] [CrossRef]
- Chelliah, R.; Ramakrishnan, S.R.; Prabhu, P.R.; Antony, U. Evaluation of antimicrobial activity and probiotic properties of wild-strain Pichia kudriavzevii isolated from frozen idli batter. Yeast 2016, 33, 385–401. [Google Scholar] [CrossRef] [PubMed]
- González-Orozco, B.D.; Kosmerl, E.; Jiménez-Flores, R.; Alvarez, V.B. Enhanced probiotic potential of Lactobacillus kefiranofaciens OSU-BDGOA1 through co-culture with Kluyveromyces marxianus bdgo-ym6. Front. Microbiol. 2023, 14, 1236634. [Google Scholar] [CrossRef]
- Elkhairy, B.M.; Salama, N.M.; Desouki, A.M.; Abdelrazek, A.B.; Soliman, K.A.; Ibrahim, S.A.; Khalil, H.B. Towards unlocking the biocontrol potential of Pichia kudriavzevii for plant fungal diseases: In vitro and in vivo assessments with candidate secreted protein prediction. BMC Microbiol. 2023, 23, 356. [Google Scholar] [CrossRef] [PubMed]
- Wang, H.; Wang, C.; Guo, M. Autogenic successions of bacteria and fungi in kefir grains from different origins when sub-cultured in goat milk. Food Res. Int. 2020, 138, 109784. [Google Scholar] [CrossRef]
- Kesenkaş, H.; Gürsoy, O.; Özbaş, H. Fermented Foods in Health and Disease Prevention; Frias, J., Martinez-Villaluenga, C., Peñas, E., Eds.; Elsevier: Amsterdam, The Netherlands, 2017; Chapter 14: Kefir. [Google Scholar]
- Azizi, N.F.; Kumar, M.R.; Yeap, S.K.; Abdullah, J.O.; Khalid, M.; Omar, A.R.; Osman, M.A.; Mortadza, S.A.S.; Alitheen, N.B. Kefir and Its Biological Activities. Foods 2021, 10, 1210. [Google Scholar] [CrossRef] [PubMed]
- Karaffová, V.; Revajová, V.; Dvorožňáková, E.; Grešáková, Ľ.; Levkut, M.; Ševčíková, Z.; Herich, R.; Levkut, M. Effect of Inorganic Zinc on Selected Immune Parameters in Chicken Blood and Jejunum after A. galli Infection. Agriculture 2021, 11, 551. [Google Scholar] [CrossRef]
- Muhialdin, B.J.; Zawawi, N.; Abdull Razis, A.F.; Bakar, J.; Zarei, M. Antiviral activity of fermented foods and their probiotics bacteria towards respiratory and alimentary tracts viruses. Food Control 2021, 127, 108140. [Google Scholar] [CrossRef] [PubMed]
- Rusu, E.; Enache, G.; Cursaru, R.; Alexescu, A.; Radu, R.; Onila, O.; Cavallioti, T.; Rusu, F.; Posea, M.; Jinga, M.; et al. Prebiotics and probiotics in atopic dermatitis. Exp. Ther. Med. 2019, 18, 926–931. [Google Scholar] [CrossRef] [PubMed]
- Prado, M.R.; Blandón, L.M.; Vandenberghe, L.P.; Rodrigues, C.; Castro, G.R.; Thomaz-Soccol, V.; Soccol, C.R. Milk kefir: Composition, microbial cultures, biological activities, and related products. Front. Microbiol. 2015, 6, 1177. [Google Scholar] [CrossRef] [PubMed]
- Talib, N.; Mohamad, N.E.; Yeap, S.K.; Hussin, Y.; Aziz, M.N.M.; Masarudin, M.J.; Sharifuddin, S.A.; Hui, Y.W.; Ho, C.L.; Alitheen, N.B. Isolation and Characterization of Lactobacillus spp. from Kefir Samples in Malaysia. Molecules 2019, 24, 2606. [Google Scholar] [CrossRef] [PubMed]
- Zanirati, D.F.; Abatemarco, M.; Sandes, S.H.d.C.; Nicoli, J.R.; Nunes, Á.C.; Neumann, E. Selection of lactic acid bacteria from Brazilian kefir grains for potential use as starter or probiotic cultures. Anaerobe 2015, 32, 70–76. [Google Scholar] [CrossRef] [PubMed]
- Carraturo, F.; De Castro, O.; Troisi, J.; De Luca, A.; Masucci, A.; Cennamo, P.; Trifuoggi, M.; Aliberti, F.; Guida, M. Comparative assessment of the quality of commercial black and green tea using microbiology analyses. BMC Microbiol. 2018, 18, 4. [Google Scholar] [CrossRef] [PubMed]
- Salbitani, G.; Chianese, M.R.; Bossa, R.; Bencivenga, T.; Carraturo, F.; Nappo, A.; Guida, M.; Loreto, F.; Carfagna, S. Cultivation of barley seedlings in a coffee silverskin-enriched soil: Effects in plants and in soil. Plant Soil 2023. [Google Scholar] [CrossRef]
- Korabecna, M.; Liska, V.; Fajfrlík, K. PrimersITS1, ITS2 andITS4 detect the intraspecies variability in the internal transcribed spacers and 5.8S rRNA gene region in clinical isolates of fungi. Folia Microbiol. 2003, 48, 233–238. [Google Scholar] [CrossRef]
- Ganapathiwar, S.; Bhukya, B. In vitro assessment for the probiotic potential of Pichia kudriavzevii. Bioinformation 2023, 19, 441–444. [Google Scholar] [CrossRef] [PubMed]
- Fadda, M.E.; Mossa, V.; Deplano, M.; Pisano, M.B.; Cosentino, S. In vitro screening of Kluyveromyces strains isolated from Fiore Sardo cheese for potential use as probiotics. LWT 2017, 75, 100–106. [Google Scholar] [CrossRef]
- Syal, P.; Vohra, A. Probiotic Potential of Yeasts Isolated from Traditional Indian Fermented Foods. Int. J. Microbiol. Res. 2013, 5, 390–398. [Google Scholar] [CrossRef]
- Zawistowska-Rojek, A.; Kośmider, A.; Stępień, K.; Tyski, S. Adhesion and aggregation properties of Lactobacillaceae strains as protection ways against enteropathogenic bacteria. Arch. Microbiol. 2022, 204, 285. [Google Scholar] [CrossRef] [PubMed]
- Maione, A.; Galdiero, E.; Cirillo, L.; Gambino, E.; Gallo, M.A.; Sasso, F.P.; Petrillo, A.; Guida, M.; Galdiero, M. Prevalence, Resistance Patterns and Biofilm Production Ability of Bacterial Uropathogens from Cases of Community-Acquired Urinary Tract Infections in South Italy. Pathogens 2023, 12, 537. [Google Scholar] [CrossRef] [PubMed]
- Stepanović, S.; Vuković, D.; Hola, V.; Di Bonaventura, G.; Djukić, S.; Cirković, I.; Ruzicka, F. Quantification of biofilm in microtiter plates: Overview of testing conditions and practical recommendations for assessment of biofilm production by staphylococci. Apmis 2007, 115, 891–899. [Google Scholar] [CrossRef] [PubMed]
- Dejene, F.; Regasa Dadi, B.; Tadesse, D. In Vitro Antagonistic Effect of Lactic Acid Bacteria Isolated from Fermented Beverage and Finfish on Pathogenic and Foodborne Pathogenic Microorganism in Ethiopia. Int. J. Microbiol. 2021, 2021, 5370556. [Google Scholar] [CrossRef]
- Chen, Z.; Leng, X.; Zhou, F.; Shen, W.; Zhang, H.; Yu, Q.; Meng, X.; Fan, H.; Qin, M. Screening and Identification of Probiotic Lactobacilli from the Infant Gut Microbiota to Alleviate Lead Toxicity. Probiotics Antimicrob. Proteins 2023, 15, 821–831. [Google Scholar] [CrossRef] [PubMed]
- Vázquez, A.; Benito, M.; Galván, A.I.; Ruiz-Moyano Seco de Herrera, S. Identification and selection of yeast with functional properties for future application in soft paste cheese. LWT 2020, 124, 109173. [Google Scholar] [CrossRef]
- Shen, Y.; Bai, X.; Zhang, Y.; Gao, Q.; Bu, X.; Xu, Y.; Guo, N. Evaluation of the Potential Probiotic Yeast Characteristics with Anti-MRSA Abilities. Probiotics Antimicrob. Proteins 2022, 14, 727–740. [Google Scholar] [CrossRef] [PubMed]
- Turchi, B.; Mancini, S.; Fratini, F.; Pedonese, F.; Nuvoloni, R.; Bertelloni, F.; Ebani, V.V.; Cerri, D. Preliminary evaluation of probiotic potential of Lactobacillus plantarum strains isolated from Italian food products. World J. Microbiol. Biotechnol. 2013, 29, 1913–1922. [Google Scholar] [CrossRef] [PubMed]
- Imparato, M.; Maione, A.; Buonanno, A.; Gesuele, R.; Gallucci, N.; Corsaro, M.M.; Paduano, L.; Casillo, A.; Guida, M.; Galdiero, E.; et al. Extracellular Vesicles from a Biofilm of a Clinical Isolate of Candida albicans Negatively Impact on Klebsiella pneumoniae Adherence and Biofilm Formation. Antibiotics 2024, 13, 80. [Google Scholar] [CrossRef]
- Maione, A.; de Alteriis, E.; Carraturo, F.; Galdiero, S.; Falanga, A.; Guida, M.; Di Cosmo, A.; Maselli, V.; Galdiero, E. The Membranotropic Peptide gH625 to Combat Mixed Candida albicans/Klebsiella pneumoniae Biofilm: Correlation between In Vitro Anti-Biofilm Activity and In Vivo Antimicrobial Protection. J. Fungi 2021, 7, 26. [Google Scholar] [CrossRef] [PubMed]
- Sourabh, A.; Kanwar, S.S.; Sharma, O.P. Screening of indigenous yeast isolates obtained from traditional fermented foods of Western Himalayas for probiotic attributes. J. Yeast Fungal Res. 2011, 2, 117–126. [Google Scholar]
- Simões, L.A.; Cristina de Souza, A.; Ferreira, I.; Melo, D.S.; Lopes, L.A.A.; Magnani, M.; Schwan, R.F.; Dias, D.R. Probiotic properties of yeasts isolated from Brazilian fermented table olives. J. Appl. Microbiol. 2021, 131, 1983–1997. [Google Scholar] [CrossRef]
- Rahmani, B.; Alimadadi, N.; Attaran, B.; Nasr, S. Yeasts from Iranian traditional milk kefir samples: Isolation, molecular identification and their potential probiotic properties. Lett. Appl. Microbiol. 2022, 75, 1264–1274. [Google Scholar] [CrossRef]
- Fonseca, H.C.; de Sousa Melo, D.; Ramos, C.L.; Dias, D.R.; Schwan, R.F. Probiotic Properties of Lactobacilli and Their Ability to Inhibit the Adhesion of Enteropathogenic Bacteria to Caco-2 and HT-29 Cells. Probiotics Antimicrob. Proteins 2021, 13, 102–112. [Google Scholar] [CrossRef]
- Salas-Jara, M.J.; Ilabaca, A.; Vega, M.; García, A. Biofilm Forming Lactobacillus: New Challenges for the Development of Probiotics. Microorganisms 2016, 4, 35. [Google Scholar] [CrossRef]
- Wasana, W.P.; Senevirathne, A.; Nikapitiya, C.; Lee, J.-S.; Kang, D.-H.; Kwon, K.K.; Oh, C.; De Zoysa, M. Probiotic effects of Pseudoalteromonas ruthenica: Antibacterial, immune stimulation and modulation of gut microbiota composition. Fish. Shellfish Immunol. 2022, 131, 229–243. [Google Scholar] [CrossRef] [PubMed]
- Lara-Hidalgo, C.E.; Dorantes-Álvarez, L.; Hernández-Sánchez, H.; Santoyo-Tepole, F.; Martínez-Torres, A.; Villa-Tanaca, L.; Hernández-Rodríguez, C. Isolation of Yeasts from Guajillo Pepper (Capsicum annuum L.) Fermentation and Study of Some Probiotic Characteristics. Probiotics Antimicrob. Proteins 2019, 11, 748–764. [Google Scholar] [CrossRef] [PubMed]
- Zheng, Z.; Wei, L.; Zhu, M.; Qian, Z.; Liu, J.; Zhang, L.; Xu, Y. Effect of lactic acid bacteria co-fermentation on antioxidant activity and metabolomic profiles of a juice made from wolfberry and longan. Food Res. Int. 2023, 174, 113547. [Google Scholar] [CrossRef] [PubMed]
- Chugh, B.; Kamal-Eldin, A. Bioactive compounds produced by probiotics in food products. Curr. Opin. Food Sci. 2020, 32, 76–82. [Google Scholar] [CrossRef]
- Markowiak, P.; Śliżewska, K. Effects of Probiotics, Prebiotics, and Synbiotics on Human Health. Nutrients 2017, 9, 1021. [Google Scholar] [CrossRef]
- Baenas, I.; Camacho-Barcia, L.; Miranda-Olivos, R.; Solé-Morata, N.; Misiolek, A.; Jiménez-Murcia, S.; Fernández-Aranda, F. Probiotic and prebiotic interventions in eating disorders: A narrative review. Eur. Eat. Disord. Rev. 2024. [Google Scholar] [CrossRef]
- Goldenberg, J.Z.; Yap, C.; Lytvyn, L.; Lo, C.K.; Beardsley, J.; Mertz, D.; Johnston, B.C. Probiotics for the prevention of Clostridium difficile-associated diarrhea in adults and children. Cochrane Database Syst. Rev. 2017, 12, Cd006095. [Google Scholar] [CrossRef] [PubMed]
- Parker, E.A.; Roy, T.; D’Adamo, C.R.; Wieland, L.S. Probiotics and gastrointestinal conditions: An overview of evidence from the Cochrane Collaboration. Nutrition 2018, 45, 125–134.e111. [Google Scholar] [CrossRef] [PubMed]
- Suez, J.; Zmora, N.; Segal, E.; Elinav, E. The pros, cons, and many unknowns of probiotics. Nat. Med. 2019, 25, 716–729. [Google Scholar] [CrossRef] [PubMed]
- Ayyash, M.M.; Abdalla, A.K.; AlKalbani, N.S.; Baig, M.A.; Turner, M.S.; Liu, S.-Q.; Shah, N.P. Invited review: Characterization of new probiotics from dairy and nondairy products—Insights into acid tolerance, bile metabolism and tolerance, and adhesion capability. J. Dairy. Sci. 2021, 104, 8363–8379. [Google Scholar] [CrossRef] [PubMed]
- Helmy, E.A.; Soliman, S.A.; Abdel-Ghany, T.M.; Ganash, M. Evaluation of potentially probiotic attributes of certain dairy yeast isolated from buffalo sweetened Karish cheese. Heliyon 2019, 5, e01649. [Google Scholar] [CrossRef] [PubMed]
- Wulan, R.; Astuti, R.I.; Rukayadi, Y.; Meryandini, A. Evaluation of Indigenous Pichia kudriavzevii from cocoa fermentation for a probiotic candidate. Biodiversitas J. Biol. Divers. 2021, 22. [Google Scholar] [CrossRef]
- Nandha, M.C.; Shukla, R.M. Exploration of probiotic attributes in lactic acid bacteria isolated from fermented Theobroma cacao L. fruit using in vitro techniques. Front. Microbiol. 2023, 14, 1274636. [Google Scholar] [CrossRef] [PubMed]
- Armas, F.; Camperio, C.; Marianelli, C. In Vitro Assessment of the Probiotic Potential of Lactococcus lactis LMG 7930 against Ruminant Mastitis-Causing Pathogens. PLoS ONE 2017, 12, e0169543. [Google Scholar] [CrossRef] [PubMed]
- Liu, C.; Xue, W.-j.; Ding, H.; An, C.; Ma, S.-j.; Liu, Y. Probiotic Potential of Lactobacillus Strains Isolated From Fermented Vegetables in Shaanxi, China. Front. Microbiol. 2022, 12, 774903. [Google Scholar] [CrossRef] [PubMed]
- Chelliah, R.; Kim, E.-J.; Daliri, E.B.-M.; Antony, U.; Oh, D.-H. In Vitro Probiotic Evaluation of Saccharomyces boulardii with Antimicrobial Spectrum in a Caenorhabditis elegans Model. Foods 2021, 10, 1428. [Google Scholar] [CrossRef] [PubMed]
- Sadeghi, M.; Panahi, B.; Mazlumi, A.; Hejazi, M.A.; Komi, D.E.A.; Nami, Y. Screening of potential probiotic lactic acid bacteria with antimicrobial properties and selection of superior bacteria for application as biocontrol using machine learning models. LWT 2022, 162, 113471. [Google Scholar] [CrossRef]
- Mahjoory, Y.; Mohammadi, R.; Hejazi, M.A.; Nami, Y. Antifungal activity of potential probiotic Limosilactobacillus fermentum strains and their role against toxigenic aflatoxin-producing aspergilli. Sci. Rep. 2023, 13, 388. [Google Scholar] [CrossRef] [PubMed]
- Shahverdi, S.; Barzegari, A.A.; Vaseghi Bakhshayesh, R.; Nami, Y. In-vitro and in-vivo antibacterial activity of potential probiotic Lactobacillus paracasei against Staphylococcus aureus and Escherichia coli. Heliyon 2023, 9, e14641. [Google Scholar] [CrossRef] [PubMed]
- Tarannum, N.; Ali, F.; Khan, M.S.; Alhumaidan, O.S.; Zawad, A.S.; Hossain, T.J. Bioactive Exopolysaccharide From Limosilactobacillus Fermentum LAB-1: Antioxidant, Anti-inflammatory, Antibacterial and Antibiofilm Properties. SSRN 2023, 10, 100409. [Google Scholar] [CrossRef]
- Liu, Y.; Gao, S.; Cui, Y.; Wang, L.; Duan, J.; Yang, X.; Liu, X.; Zhang, S.; Sun, B.; Yu, H.; et al. Characteristics of Lactic Acid Bacteria as Potential Probiotic Starters and Their Effects on the Quality of Fermented Sausages. Foods 2024, 13, 198. [Google Scholar] [CrossRef] [PubMed]
- Feng, T.; Wang, J. Oxidative stress tolerance and antioxidant capacity of lactic acid bacteria as probiotic: A systematic review. Gut Microbes 2020, 12, 1801944. [Google Scholar] [CrossRef]
- Unban, K.; Chaichana, W.; Baipong, S.; Abdullahi, A.D.; Kanpiengjai, A.; Shetty, K.; Khanongnuch, C. Probiotic and Antioxidant Properties of Lactic Acid Bacteria Isolated from Indigenous Fermented Tea Leaves (Miang) of North Thailand and Promising Application in Synbiotic Formulation. Fermentation 2021, 7, 195. [Google Scholar] [CrossRef]
- Kang, C.-H.; Kim, J.-S.; Park, H.M.; Kim, S.; Paek, N.-S. Antioxidant activity and short-chain fatty acid production of lactic acid bacteria isolated from Korean individuals and fermented foods. 3 Biotech 2021, 11, 217. [Google Scholar] [CrossRef] [PubMed]
- Czerucka, D.; Piche, T.; Rampal, P. Review article: Yeast as probiotics—Saccharomyces boulardii. Aliment. Pharmacol. Ther. 2007, 26, 767–778. [Google Scholar] [CrossRef] [PubMed]
- Zommiti, M.; Connil, N.; Hamida, J.B.; Ferchichi, M. Probiotic Characteristics of Lactobacillus curvatus DN317, a Strain Isolated from Chicken Ceca. Probiotics Antimicrob. Proteins 2017, 9, 415–424. [Google Scholar] [CrossRef]
- Tarannum, N.; Hossain, T.J.; Ali, F.; Das, T.; Dhar, K.; Nafiz, I.H. Antioxidant, antimicrobial and emulsification properties of exopolysaccharides from lactic acid bacteria of bovine milk: Insights from biochemical and genomic analysis. LWT 2023, 186, 115263. [Google Scholar] [CrossRef]
- Mishra, A.K.; Ghosh, A.R. Characterization of Functional, Safety, and Probiotic Properties of Enterococcus faecalis AG5 Isolated From Wistar Rat, Demonstrating Adherence to HCT 116 Cells and Gastrointestinal Survivability. Probiotics Antimicrob. Proteins 2018, 10, 435–445. [Google Scholar] [CrossRef] [PubMed]
- Tran, K.-D.; Le-Thi, L.; Vo, H.-H.; Dinh-Thi, T.-V.; Nguyen-Thi, T.; Phan, N.-H.; Nguyen, K.-U. Probiotic Properties and Safety Evaluation in the Invertebrate Model Host Galleria mellonella of the Pichia kudriavzevii YGM091 Strain Isolated from Fermented Goat Milk. Probiotics Antimicrob. Proteins 2023. [Google Scholar] [CrossRef]

| Internal Code | Identified Microorganism | Max Score | Total Score | Query Cover | e-Value | % Identity | Accession N. |
|---|---|---|---|---|---|---|---|
| LAB1 | Lactococcus lactis subsp. hordniae strain V4048 | 1256 | 1256 | 98% | 0.0 | 99.57% | OR755425.1 |
| LAB2 | Lactococcus lactis subsp. lactis strain NM26-6 | 1286 | 1286 | 99% | 0.0 | 99.72% | HM218132.1 |
| Y1 | Pichia kudriavzevii strain CBS 5147 | 1037 | 1037 | 99% | 0.0 | 99.65% | MH545928.1 |
| E. coli ATCC 25922 | L. monocytogenes ATCC 7644 | Salmonella spp. S1 | Salmonella spp. S2 | Salmonella spp. S3 | Salmonella spp. S4 | |||||||
|---|---|---|---|---|---|---|---|---|---|---|---|---|
| Time (h) | 2 | 4 | 2 | 4 | 2 | 4 | 2 | 4 | 2 | 4 | 2 | 4 |
| Y1 | 36.3 a ± 1.4 | 79.1 b ± 1.4 | 43.3 a ± 2.1 | 81.6 b ± 1.3 | 10.9 c ± 1.1 | 68.2 b ± 2.3 | 14.6 c ± 0.4 | 51.9 d ± 3.2 | 32.1 a ± 1.6 | 82.6 b ± 2.7 | 40.3 a ± 1.6 | 79.8 b ± 2.5 |
| LAB1 | 8.0 a ± 1.6 | 25.3 b ± 2.0 | 7.0 a ± 0.5 | 31.3 c ± 2.5 | 6.2 a ± 0.3 | 34.1 c ± 1.4 | 10.2 a ± 2.3 | 44.0 d ± 1.5 | 18.1 e ± 0.5 | 30.0 c ± 1.0 | 7.6 a ± 0.2 | 21.3 e ± 1.5 |
| LAB2 | 9.0 a ± 1.1 | 22.5 b ± 2.1 | 6.4 a ± 0.9 | 24.9 b ± 2.3 | 17.2 c ± 1.4 | 29.6 b ± 1.9 | 21.0 b ± 2.8 | 51.2 e ± 3.1 | 15.1 c ± 1.5 | 28.3 b ± 0.3 | 9.7 a ± 1.4 | 20.7 b ± 2.8 |
| OD570 | CFU/mL | Classification | ||
|---|---|---|---|---|
| Y | LAB | |||
| Y1 | 0.246 | 1.7 × 104 | - | moderate |
| LAB1 | 0.148 | - | 4.0 × 103 | weak |
| LAB2 | 0.159 | - | 1.4 × 103 | weak |
| Y1 + LAB1 | 0.299 | 3.1 × 104 | 8.1 × 103 | moderate |
| Y1 + LAB2 | 0.231 | 2.0 × 104 | 6.5 × 103 | moderate |
| Y1 + LAB1 + LAB2 | 0.397 | 2.1 × 104 | 3.3 × 104 | moderate |
| CFS-Y1 | CFS-LAB1 | CFS-LAB2 | CFS-MIX | |
|---|---|---|---|---|
| Ø mm | ||||
| E. coli ATCC 25922 | - | - | - | - |
| L. monocytogenes ATCC 7644 | - | 11.5 a | 12.6 a | 11.3 a |
| Salmonella spp. S1 | - | 8.2 b | 8.0 b | 10.2 a |
| Salmonella spp. S2 | - | - | - | - |
| Salmonella spp. S3 | - | 7.1 b | 7.9 b | 8.7 b |
| Salmonella spp. S4 | - | 11.0 a | 11.9 a | 12.2 a |
| GM | AMP | PB | AMC | NOR | STR | CTX | CIP | AZ | CRO | VAN | RIF | FLC | CSF | KET | ITR | AmpB | |
|---|---|---|---|---|---|---|---|---|---|---|---|---|---|---|---|---|---|
| Y1 | R | R | R | R | R | R | R | R | R | R | R | R | S | S | S | R | S |
| Lab1 | S | S | S | S | S | S | S | S | S | S | S | S | - | - | - | - | - |
| Lab2 | S | S | S | S | S | S | S | S | S | S | S | S | - | - | - | - | - |
| Injection Doses | Yeast Density (CFU/mL) |
|---|---|
| 1 × 104 | 1.3 ± 0.45 × 103 a |
| 1 × 105 | 1.4 ± 0.38 × 103 a |
| 1 × 106 | 6.5 ± 0.06 × 103 a |
| 1 × 107 | 7.9 ± 0.25 × 105 b |
Disclaimer/Publisher’s Note: The statements, opinions and data contained in all publications are solely those of the individual author(s) and contributor(s) and not of MDPI and/or the editor(s). MDPI and/or the editor(s) disclaim responsibility for any injury to people or property resulting from any ideas, methods, instructions or products referred to in the content. |
© 2024 by the authors. Licensee MDPI, Basel, Switzerland. This article is an open access article distributed under the terms and conditions of the Creative Commons Attribution (CC BY) license (https://creativecommons.org/licenses/by/4.0/).
Share and Cite
Maione, A.; Imparato, M.; Buonanno, A.; Salvatore, M.M.; Carraturo, F.; de Alteriis, E.; Guida, M.; Galdiero, E. Evaluation of Potential Probiotic Properties and In Vivo Safety of Lactic Acid Bacteria and Yeast Strains Isolated from Traditional Home-Made Kefir. Foods 2024, 13, 1013. https://doi.org/10.3390/foods13071013
Maione A, Imparato M, Buonanno A, Salvatore MM, Carraturo F, de Alteriis E, Guida M, Galdiero E. Evaluation of Potential Probiotic Properties and In Vivo Safety of Lactic Acid Bacteria and Yeast Strains Isolated from Traditional Home-Made Kefir. Foods. 2024; 13(7):1013. https://doi.org/10.3390/foods13071013
Chicago/Turabian StyleMaione, Angela, Marianna Imparato, Annalisa Buonanno, Maria Michela Salvatore, Federica Carraturo, Elisabetta de Alteriis, Marco Guida, and Emilia Galdiero. 2024. "Evaluation of Potential Probiotic Properties and In Vivo Safety of Lactic Acid Bacteria and Yeast Strains Isolated from Traditional Home-Made Kefir" Foods 13, no. 7: 1013. https://doi.org/10.3390/foods13071013
APA StyleMaione, A., Imparato, M., Buonanno, A., Salvatore, M. M., Carraturo, F., de Alteriis, E., Guida, M., & Galdiero, E. (2024). Evaluation of Potential Probiotic Properties and In Vivo Safety of Lactic Acid Bacteria and Yeast Strains Isolated from Traditional Home-Made Kefir. Foods, 13(7), 1013. https://doi.org/10.3390/foods13071013









